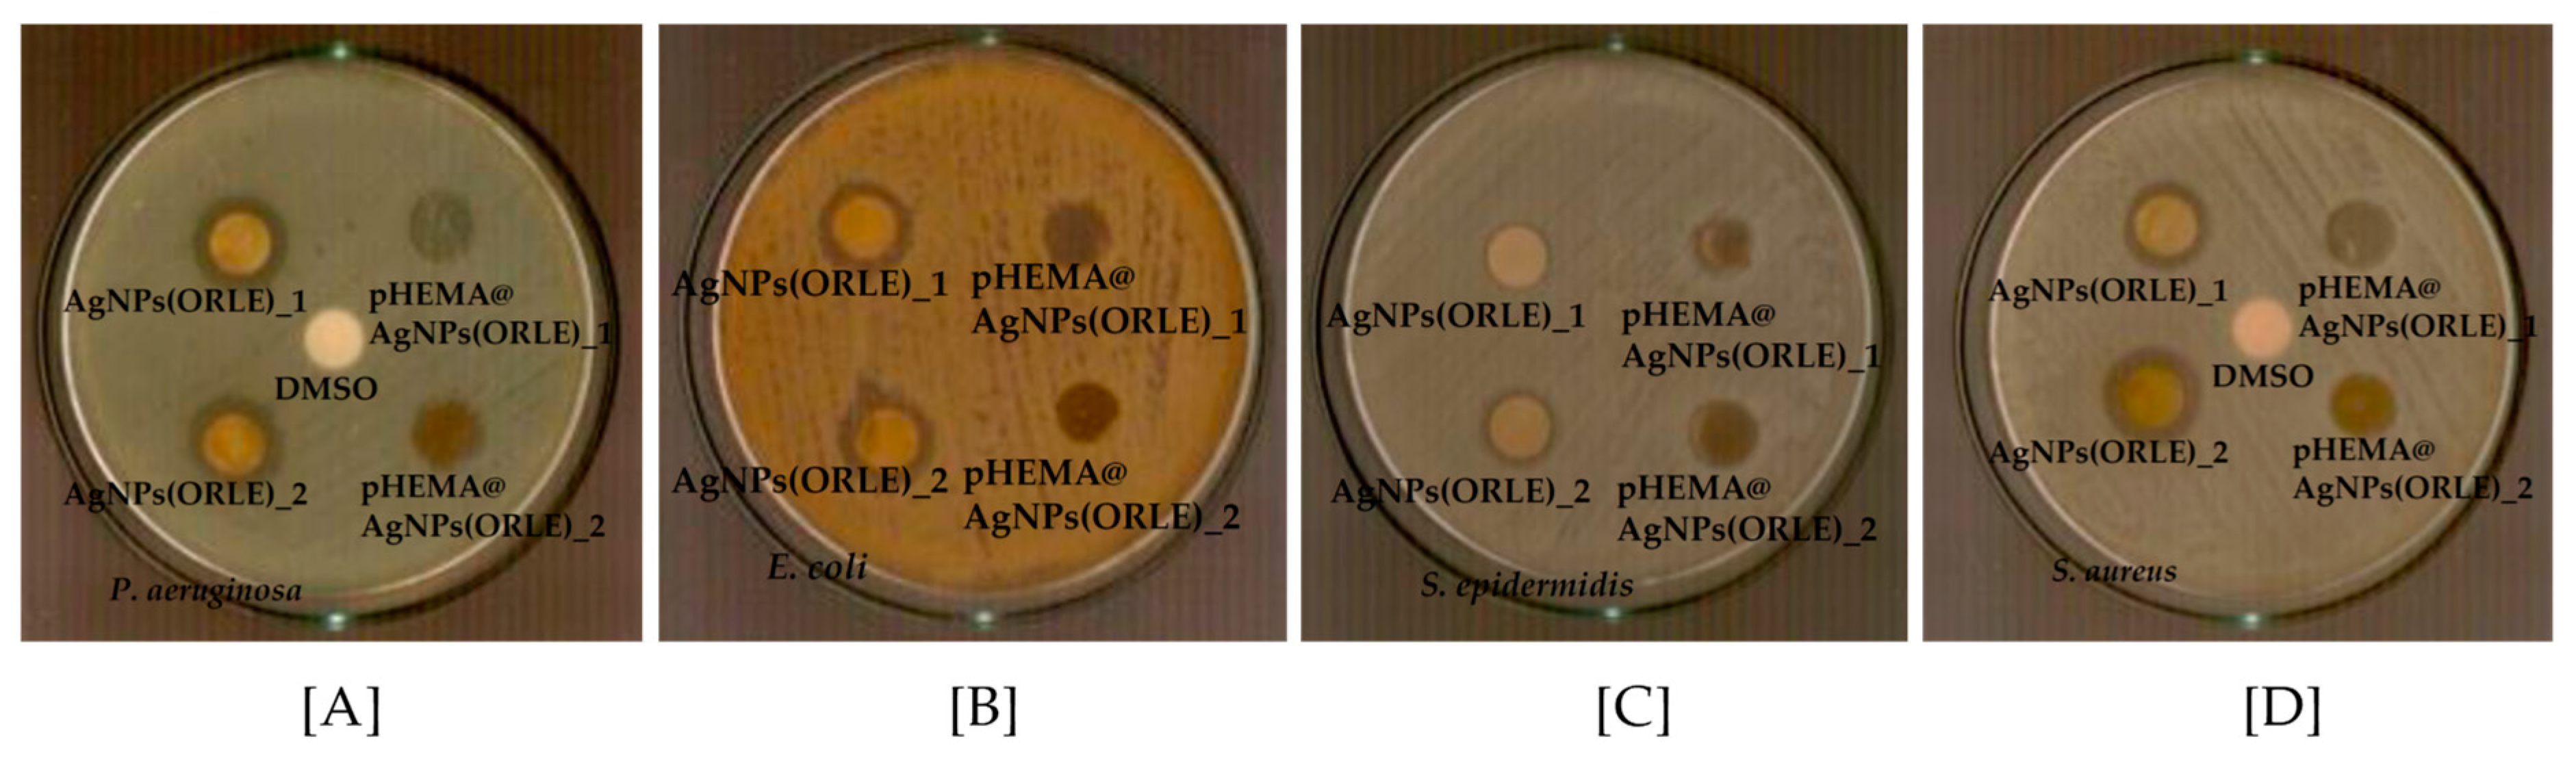
Ijms 22 03539 g007

Silver Nanoparticles from Oregano Leaves’ Extracts as Antimicrobial Components for Non-Infected Hydrogel Contact Lenses
Abstract
1. Introduction
2. Results
2.1. General Aspects
2.2. Solid State
2.2.1. Refractive Index
2.2.2. X-ray Fluorescence Spectroscopy
2.2.3. X-ray Powder Diffraction Analysis (XRPD)
2.2.4. Thermogravimetric Analysis of AgNPs(ORLE), pHEMA, and pHEMA@AgNPs(ORLE)_2
Differential Scanning Calorimetry (DSC)
Thermal Decomposition of AgNPs(ORLE) and The Composite pHEMA@AgNPs(ORLE)_2
2.2.5. Ultraviolet-Visible Spectroscopy (UV–Vis)
Solid State UV–Vis Spectra
Solution State Spectra
2.3. Antibacterial Activity of ORLE and AgNPs(ORLE)
2.3.1. Determination of the Inhibition Zone (IZ) through Agar Disc-Diffusion Method
2.3.2. Effects on Biofilm Formation
2.3.3. Minimum Inhibitory (MIC) and Minimum Bactericidal (MBC) Concentrations
2.3.4. Effects on Biofilm Formation by AgNPs(ORLE)
2.3.5. In Vitro Toxicity against Normal Human Corneal Epithelial Cells (HCECs)
2.3.6. In Vivo Toxicity Evaluation by Brine Shrimp Artemia Salina
3. Materials and Methods
3.1. Materials and Instruments
3.2. Preparation of ORLE and AgNPs(ORLE)
3.3. Synthesis of pHEMA@ORLE_2 and pHEMA@AgNPs(ORLE)_2
3.4. Refractive Indexes
3.5. X-ray Fluorescence Spectroscopy
3.6. X-ray Powder Diffraction (XRPD)
3.7. Thermogravimetric Differential Thermal Analysis (TG-DTA), Differential Scanning Calorimetry (DTG/DSC)
3.8. Bacterial Strains
3.9. Effects on the Growth of Microbial Strains
3.10. Removal of Biofilm, Using Crystal Violet Assay
3.11. Determination of the Inhibition Zone (IZ)
3.12. Sulforhodamine B Assay
3.13. Evaluation of Toxicity with Brine Shrimp Assay
4. Conclusions
Supplementary Materials
Author Contributions
Funding
Institutional Review Board Statement
Informed Consent Statement
Acknowledgments
Conflicts of Interest
Abbreviations
| ATR–FT–IR | Attenuated Total Reflection mode |
| ΒΕC | Biofilm Elimination Concentration |
| DTG/DSC | Differential Scanning Calorimetry |
| E. coli | Escherichia coli |
| FWHM | Full Width at Half Maximum |
| HCEC | Normal Human Corneal Epithelial Cells |
| IZ | Inhibitory Zone |
| MBC | Minimum Bactericidal Concentration |
| MIC | Minimum Inhibitory Concentration |
| MK | Microbial Keratitis |
| P. aeruginosa | Pseudomonas aeruginosa |
| pHEMA | poly–2–hydroxyethylmethacrylate |
| S. aureus | Staphylococcus aureus |
| S. epidermidis | Staphylococcus epidermidis |
| TD–DTA | Thermogravimetric Differential Thermal Analysis |
| UV–Vis | Ultra violet |
| XRF | X-ray fluorescence spectroscopy |
| XRPD | X-ray powder diffraction analysis |
References
- Musgrave, C.S.A.; Fang, F. Contact Lens Materials: A Materials Science Perspective. Materials 2019, 12, 261. [Google Scholar] [CrossRef]
- Wichterle, O.; Lim, D. Hydrophilic Gels for Biological Use. Nature 1960, 185, 117–118. [Google Scholar] [CrossRef]
- Caló, E.; Khutoryanskiy, V.V. Biomedical applications of hydrogels: A review of patents and commercial products. Eur. Polym. J. 2015, 65, 252–267. [Google Scholar] [CrossRef]
- Schaefer, F.; Bruttin, O.; Zografos, L.; Guex-Crosier, Y. Bacterial keratitis: A prospective clinical and microbiological study. Br. J. Ophthalmol. 2001, 85, 842–847. [Google Scholar] [CrossRef] [PubMed]
- Stapleton, F.; Carnt, N. Contact lens–related microbial keratitis: How have epidemiology and genetics helped us with pathogenesis and prophylaxis. Eye 2012, 26, 185–193. [Google Scholar] [CrossRef]
- Milionis, I.; Banti, C.B.; Sainis, I.; Raptopoulou, C.P.; Psycharis, V.; Kourkoumelis, N.; Hadjikakou, S.K. Silver ciprofloxacin (CIPAG): A successful combination of chemically modified antibiotic in inorganic–organic hybrid. J. Biol. Inorg. Chem. 2018, 23, 705–723. [Google Scholar] [CrossRef] [PubMed]
- Rossos, A.K.; Banti, C.N.; Kalampounias, A.; Papachristodoulou, C.; Kordatos, K.; Zoumpoulakis, P.; Mavromoustakos, T.; Kourkoumelis, N.; Hadjikakou, S.K. pHEMA@AGMNA–1: A novel material for the development of antibacterial contact lens. Mater. Sci. Eng. C 2020, 111, 110770. [Google Scholar] [CrossRef]
- Xiao, A.; Dhand, C.; Leung, C.M.; Beuerman, R.W.; Ramakrishna, S.; Lakshminarayanan, R. Strategies to Design Antimicrobial Contact Lenses and Contact Lens Cases. J. Mater. Chem. B 2018, 6, 2171–2186. [Google Scholar] [CrossRef]
- Rai, M.; Yadav, A.; Gade, A. Silver nanoparticles as a new generation of antimicrobials. Biotechnol. Adv. 2009, 27, 76–83. [Google Scholar] [CrossRef]
- Maciel, M.V.D.O.B.; da Rosa Almeida, A.; Machado, M.H.; Elias, W.C.; da Rosa, C.G.; Teixeira, G.L.; Noronha, C.M.; Bertoldi, F.C.; Nunes, M.R.; de Armas, R.D.; et al. Green synthesis, characteristics and antimicrobial activity of silver nanoparticles mediated by essential oils as reducing agents, Biocatal. Agric. Biotechnol. 2020, 28, 101746. [Google Scholar]
- Rodriguez-Garcia, I.; Silva-Espinoza, B.A.; Ortega-Ramirez, L.A.; Leyva, J.M.; Siddiqui, M.W.; Cruz-Valenzuela, M.R.; Gonzalez-Aguilar, G.A.; Ayala-Zavala, J.F. Oregano Essential Oil as an Antimicrobial and Antioxidant Additive in Food Products. Crit. Rev. Food Sci. Nutr. 2016, 56, 1717–1727. [Google Scholar] [CrossRef] [PubMed]
- Rahimi-Nasrabadi, M.; Mahdi Pourmortazavi, S.; Ataollah Sadat Shandiz, S.; Ahmadi, F.; Batooli, H. Green synthesis of silver nanoparticles using Eucalyptus leucoxylon leaves extract and evaluating the antioxidant activities of extract. Nat. Prod. Res. 2014, 28, 1964–1969. [Google Scholar] [CrossRef] [PubMed]
- Hambardzumyan, S.; Sahakyan, N.; Petrosyan, M.; Jawad Nasim, M.; Jacob, C.; Trchounian, A. Origanum vulgare L. extract–mediated synthesis of silver nanoparticles, their characterization and antibacterial activities. AMB Express 2020, 10, 162. [Google Scholar] [CrossRef]
- Shaik, M.R.; Khan, M.; Kuniyil, M.; Al-Warthan, A.; Alkhathlan, H.Z.; Siddiqui, M.R.H.; Shaik, J.P.; Ahamed, A.; Mahmood, A.; Khan, M.; et al. Plant-Extract-Assisted Green Synthesis of Silver Nanoparticles Using Origanum vulgare L. Extract and Their Microbicidal Activities. Sustainability 2018, 10, 913. [Google Scholar]
- Varikooty, J.; Keir, N.; Woods, C.A.; Fonn, D. Measurement of the refractive index of soft contact lenses during wear. Eye Contact Lens 2010, 36, 2–5. [Google Scholar] [CrossRef]
- Childs, A.; Li, H.; Lewittes, D.; Dong, B.; Liu, W.; Shu, X.; Sun, C.; Zhang, H.F. Fabricating customized hydrogel contact lens. Sci. Rep. 2016, 6, 34905. [Google Scholar] [CrossRef]
- Abdel-Halim, E.S.; Alanazi, H.H.; Al-Deyab, S.S. Utilization of hydroxypropyl carboxymethyl cellulose in synthesis of silver nanoparticles. Int. J. Biol. Macromol. 2015, 75, 467–473. [Google Scholar] [CrossRef] [PubMed]
- Garza-Navarro, M.A.; Aguirre-Rosales, J.A.; Llanas-Vázquez, E.E.; Moreno-Cortez, I.E.; Torres-Castro, A.; González-González, V. Totally ecofriendly synthesis of silver nanoparticles from aqueous dissolutions of polysaccharides. Int. J. Polym. Sci. 2013, 436021. [Google Scholar] [CrossRef]
- Oldenburg, S.J. Silver Nanoparticles: Properties and Applications, Sigma–Aldrich. Available online: www.sigmaaldrich.com/technical–documents/articles/materials–science/nanomaterials/silver–nanoparticles.html.
- Matuschek, E.; Brown, D.F.J.; Kahlmeter, G. Development of the EUCAST disk difusion antimicrobial susceptibility testing method and its implementation in routine microbiology laboratories. Clin. Microbiol. Infect. 2014, 20, o255–o266. [Google Scholar] [CrossRef] [PubMed]
- Clinical and Laboratory Standards Institute (CLSI). Performance Standards for Antimicrobial Susceptibility Testing; Approved Standard, 25th Informational Supplement, CLSI document M100–S25; Clinical and Laboratory Standards Institute: Wayne, PA, USA, 2015. [Google Scholar]
- Doroshenko, N.; Rimmer, S.; Hoskins, R.; Garg, P.; Swift, T.; Spencer, H.L.M.; Lord, R.M.; Katsikogianni, M.; Pownall, D.; MacNeil, S.; et al. Antibiotic functionalised polymers reduce bacterial biofilm and bioburden in a simulated infection of the cornea. Biomater. Sci. 2018, 6, 2101–2109. [Google Scholar] [CrossRef] [PubMed]
- Karetsi, V.A.; Banti, C.N.; Kourkoumelis, N.; Papachristodoulou, C.; Stalikas, C.D.; Raptopoulou, C.P.; Psycharis, V.; Zoumpoulakis, P.; Mavromoustakos, T.; Sainis, I.; et al. An Efficient Disinfectant, Composite Material {SLS@[Zn3(CitH)2]} as Ingredient for Development of Sterilized and Non Infectious Contact Lens. Antibiotics 2019, 8, 213. [Google Scholar] [CrossRef] [PubMed]
- Wiegand, I.; Hilpert, K.; Hancock, R.E.W. Agar and broth dilution methods to determine the minimal inhibitory concentration (MIC) of antimicrobial substances. Nat. Protoc. 2008, 3, 163–175. [Google Scholar] [CrossRef] [PubMed]
- Zhu, B.; Zhu, S.; Li, J.; Hui, X.; Wang, G.-X. The developmental toxicity, bioaccumulation and distribution of oxidized single walled carbon nanotubes in Artemia salina. Toxicol. Res. 2018, 7, 897–906. [Google Scholar] [CrossRef]
- Banti, C.N.; Hadjikakou, S.K. Evaluation of Toxicity with Brine Shrimp Assay. Bio Protoc. 2020, 11, e3895. [Google Scholar] [CrossRef]
- Trompeta, A.F.; Preiss, I.; Ben-Ami, F.; Benayahu, Y.; Charitidis, C.A. Toxicity testing of MWCNTs to aquatic organisms. RSC Adv. 2019, 9, 36707–36716. [Google Scholar] [CrossRef]
- da Silveira Carvalho, J.M.; de Morais Batista, A.H.; Nogueira, N.A.P.; Holanda, A.K.M.; de Sousa, J.R.; Zampieri, D.; Bezerra, M.J.B.; Barreto, F.S.; de Moraes, M.O.; Batista, A.A.; et al. A biphosphinic ruthenium complex with potent anti–bacterial and anti–cancer activity. New J. Chem. 2017, 41, 13085–13095. [Google Scholar] [CrossRef]
- Živković, M.B.; Matić, I.Z.; Rodić, M.V.; Novaković, I.T.; Sladić, D.M.; Krstić, N.M. Synthesis, characterization and in vitro cytotoxic activities of new steroidal thiosemicarbazones and thiadiazolines. RSC Adv. 2016, 6, 34312–34333. [Google Scholar] [CrossRef]
- Ketikidis, I.; Banti, C.N.; Kourkoumelis, N.; Tsiafoulis, C.G.; Papachristodoulou, C.; Kalampounias, A.G.; Hadjikakou, S.K. Conjugation of Penicillin–G with Silver(I) Ions Expands Its Antimicrobial Activity against Gram Negative Bacteria. Antibiotics 2020, 9, 25. [Google Scholar] [CrossRef]

| Material Title | P. aeuroginosa | E. coli | S. epidermidis | S. aureus |
|---|---|---|---|---|
| IZ (mm) | ||||
| AgNPs(ORLE) 2 mg/mL | 13.1 ± 1.6 | 12.3 ± 0.7 | 12.7 ± 1.7 | 14.8 ± 1.1 |
| ORLE 2 mg/mL | 10.2 ± 0.7 | 9.3 ± 0.5 | ND | ND |
| pHEMA@AgNPs(ORLE)_2 | 10.3 ± 0.7 | ND | 11.0 ± 1.9 | 10.3 ± 0.7 |
| pHEMA@ORLE_2 | ND | ND | ND | ND |
| Bacteria Viability (%) | ||||
| pHEMA@AgNPs(ORLE)_2 | 66.5 | 88.3 | 77.7 | 59.6 |
| pHEMA@ORLE_2 | 89.3 | 88.1 | 92.8 | 84.6 |
| MIC (μg/mL) | ||||
| AgNPs(ORLE) | 139.5 ± 17.4 | 124.3 ± 12.9 | 272.2 ± 14.1 | >300 |
| ORLE | >300 | >300 | >300 | >300 |
| MBC (μg/mL) | ||||
| AgNPs(ORLE) | 135.7 ± 35.2 | >300 | >300 | >300 |
| ORLE | >300 | >300 | >300 | >300 |
| BEC (μg/mL) | ||||
| AgNPs(ORLE) | 945 ± 72 | – | – | >1000 |
| Tested Concentration (μg/mL) | % Mortality | |
|---|---|---|
| ORLE | AgNPs(ORLE) | |
| 150 | 4.0 ± 3.3 | 7.1 ± 3.4 |
| 200 | 33.9 ± 9.9 | 36.6 ± 11.6 |
| 250 | 34.5 ± 14.1 | 26.4 ± 11.4 |
| 300 | 78.4 ± 13.4 | 78.8 ± 23.1 |
Publisher’s Note: MDPI stays neutral with regard to jurisdictional claims in published maps and institutional affiliations. |
© 2021 by the authors. Licensee MDPI, Basel, Switzerland. This article is an open access article distributed under the terms and conditions of the Creative Commons Attribution (CC BY) license (http://creativecommons.org/licenses/by/4.0/).
Share and Cite
Meretoudi, A.; Banti, C.N.; Raptis, P.K.; Papachristodoulou, C.; Kourkoumelis, N.; Ikiades, A.A.; Zoumpoulakis, P.; Mavromoustakos, T.; Hadjikakou, S.K. Silver Nanoparticles from Oregano Leaves’ Extracts as Antimicrobial Components for Non-Infected Hydrogel Contact Lenses. Int. J. Mol. Sci. 2021, 22, 3539. https://doi.org/10.3390/ijms22073539
Meretoudi A, Banti CN, Raptis PK, Papachristodoulou C, Kourkoumelis N, Ikiades AA, Zoumpoulakis P, Mavromoustakos T, Hadjikakou SK. Silver Nanoparticles from Oregano Leaves’ Extracts as Antimicrobial Components for Non-Infected Hydrogel Contact Lenses. International Journal of Molecular Sciences. 2021; 22(7):3539. https://doi.org/10.3390/ijms22073539
Chicago/Turabian StyleMeretoudi, Anastasia, Christina N. Banti, Panagiotis K. Raptis, Christina Papachristodoulou, Nikolaos Kourkoumelis, Aris A. Ikiades, Panagiotis Zoumpoulakis, Thomas Mavromoustakos, and Sotiris K. Hadjikakou. 2021. "Silver Nanoparticles from Oregano Leaves’ Extracts as Antimicrobial Components for Non-Infected Hydrogel Contact Lenses" International Journal of Molecular Sciences 22, no. 7: 3539. https://doi.org/10.3390/ijms22073539
APA StyleMeretoudi, A., Banti, C. N., Raptis, P. K., Papachristodoulou, C., Kourkoumelis, N., Ikiades, A. A., Zoumpoulakis, P., Mavromoustakos, T., & Hadjikakou, S. K. (2021). Silver Nanoparticles from Oregano Leaves’ Extracts as Antimicrobial Components for Non-Infected Hydrogel Contact Lenses. International Journal of Molecular Sciences, 22(7), 3539. https://doi.org/10.3390/ijms22073539

